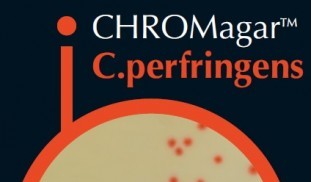
ChromAgar.jpg

จุดสนใจ spotlight
อาหารเลี้ยงเชื้อ CHROMagar, Chromogenic medium (1Lbs.) with supplement(s)
For detection and enumeration of Clostridium perfringens
For detection, differentiation and enumeration of thermotolerant Campylobacter
For the detection of Candida spp.
มีเดีย 1 ขวด (238.5 กรัม) สามารถเตรียมอาหารเลี้ยงเชื้อ ได้รวม 5ลิตร หรือ ประมาณ ทดสอบได้ จำนวน 250 ตัวอย่าง ( 20mL ในเพลทขนาด 90mm/ตัวอย่าง)